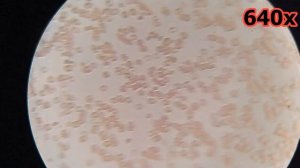
Кровь после газированной воды

1:25:51
1:25:51
2024-04-18 19:13

 3:16
3:16

 3:16
3:16
2025-09-08 23:44

 0:28
0:28

 0:28
0:28
2024-04-04 11:49

 6:12
6:12

 6:12
6:12
2024-08-17 13:46

 11:00
11:00

 11:00
11:00
2024-12-17 21:46

 30:30
30:30

 30:30
30:30
2024-10-04 07:25

 2:22
2:22

 2:22
2:22
2023-11-10 15:24

 35:52
35:52

 35:52
35:52
2024-10-17 09:00

 5:45
5:45

 5:45
5:45
2024-08-17 17:04

 1:01:18
1:01:18

 1:01:18
1:01:18
2024-02-01 09:41

 2:06
2:06
2:06
2:06
2023-11-06 19:44

 0:58
0:58

 0:58
0:58
2022-01-30 18:20

 1:30
1:30

 1:30
1:30
2023-03-11 16:05

 2:09
2:09

 2:09
2:09
2023-09-19 13:29

 34:00
34:00

 34:00
34:00
2023-08-07 20:52

 1:37:49
1:37:49

 1:37:49
1:37:49
2021-04-16 17:30

 12:10
12:10

 12:10
12:10
2025-01-21 16:33

 25:30
25:30
![Руслан Гасанов, Роман Ткаченко - Друзьям (Премьера клипа 2025)]() 3:20
3:20
![Зафар Эргашов - Мусофирда каридим (Премьера клипа 2025)]() 4:58
4:58
![Жасурбек Мирзажонов - Суймаганга суйкалдим (Премьера клипа 2025)]() 5:45
5:45
![Сергей Завьялов - В дороге (Премьера клипа 2025)]() 3:14
3:14
![Зара - Танго о двух влюбленных кораблях (Премьера клипа 2025)]() 3:10
3:10
![MEDNA - Алё (Премьера клипа 2025)]() 2:28
2:28
![Рейсан Магомедкеримов, Ренат Омаров - Бла-та-та (Премьера клипа 2025)]() 2:26
2:26
![Инна Вальтер - Роза (Премьера клипа 2025)]() 3:18
3:18
![Шерзодбек Жонибеков - Дадажон (Премьера клипа 2025)]() 3:02
3:02
![Артур Халатов - Девочка моя (Премьера клипа 2025)]() 2:37
2:37
![Magas - Без тебя (Премьера клипа 2025)]() 2:28
2:28
![Zhamil Turan - Капали (Премьера клипа 2025)]() 3:08
3:08
![Бьянка - Бренд (Премьера клипа 2025)]() 2:29
2:29
![SHAXO - Негодяйка (Премьера клипа 2025)]() 3:27
3:27
![Дана Лахова - Одинокая луна (Премьера клипа 2025)]() 2:15
2:15
![Алмас Багратиони - Сила веры (Премьера клипа 2025)]() 3:18
3:18
![Сардор Расулов - Етолмадим (Премьера клипа 2025)]() 4:15
4:15
![Selena Gomez - In The Dark (Official Video 2025)]() 3:04
3:04
![ARTEE - Лети (Премьера клипа 2025)]() 3:13
3:13
![Азимжон Сайфуллаев - Тупрок буламиз (Премьера клипа 2025)]() 4:38
4:38
![Хани, не надо! | Honey Don't! (2025)]() 1:29:32
1:29:32
![Большое смелое красивое путешествие | A Big Bold Beautiful Journey (2025)]() 1:49:20
1:49:20
![Когда ты закончишь спасать мир | When You Finish Saving the World (2022)]() 1:27:40
1:27:40
![F1 (2025)]() 2:35:53
2:35:53
![Псы войны | Hounds of War (2024)]() 1:34:38
1:34:38
![Только ты | All of You (2025)]() 1:38:22
1:38:22
![Четверо похорон и одна свадьба | Plots with a View (2002)]() 1:32:52
1:32:52
![Дом из динамита | A House of Dynamite (2025)]() 1:55:08
1:55:08
![Плохой Cанта 2 | Bad Santa 2 (2016) (Гоблин)]() 1:28:32
1:28:32
![Терминатор 2: Судный день | Terminator 2: Judgment Day (1991) (Гоблин)]() 2:36:13
2:36:13
![Хищник | Predator (1987) (Гоблин)]() 1:46:40
1:46:40
![Чумовая пятница 2 | Freakier Friday (2025)]() 1:50:38
1:50:38
![Заклятие 4: Последний обряд | The Conjuring: Last Rites (2025)]() 2:15:54
2:15:54
![Эффект бабочки | The Butterfly Effect (2003)]() 1:53:35
1:53:35
![Храброе сердце | Braveheart (1995)]() 2:57:46
2:57:46
![Французский любовник | French Lover (2025)]() 2:02:20
2:02:20
![Лучшее Рождество! | Nativity! (2009)]() 1:46:00
1:46:00
![Пойман с поличным | Caught Stealing (2025)]() 1:46:45
1:46:45
![Мужчина у меня в подвале | The Man in My Basement (2025)]() 1:54:48
1:54:48
![Сверху вниз | Highest 2 Lowest (2025)]() 2:13:21
2:13:21
![Хвостатые песенки]() 7:00
7:00
![Рэй и пожарный патруль Сезон 1]() 13:27
13:27
![Оранжевая корова]() 6:30
6:30
![Лудлвилль]() 7:09
7:09
![Ну, погоди! Каникулы]() 7:09
7:09
![Отряд А. Игрушки-спасатели]() 13:06
13:06
![Зебра в клеточку]() 6:30
6:30
![Сборники «Приключения Пети и Волка»]() 1:50:38
1:50:38
![Котёнок Шмяк]() 11:04
11:04
![Забавные медвежата]() 13:00
13:00
![Сборники «Умка»]() 1:20:52
1:20:52
![МиниФорс Сезон 1]() 13:12
13:12
![Тёплая анимация | Новая авторская анимация Союзмультфильма]() 10:21
10:21
![Люк - путешественник во времени]() 1:19:50
1:19:50
![Супер Дино]() 12:41
12:41
![Команда Дино. Исследователи Сезон 1]() 13:10
13:10
![Карли – искательница приключений. Древнее королевство]() 13:00
13:00
![Пиратская школа]() 11:06
11:06
![Команда Дино Сезон 1]() 12:08
12:08
![Чемпионы]() 7:21
7:21

 25:30
25:30Скачать видео
| 256x144 | ||
| 426x240 | ||
| 640x360 | ||
| 854x480 | ||
| 1280x720 |
 3:20
3:20
2025-10-25 12:59
 4:58
4:58
2025-10-18 10:31
 5:45
5:45
2025-10-27 13:06
 3:14
3:14
2025-10-29 10:28
 3:10
3:10
2025-10-27 10:52
 2:28
2:28
2025-10-21 09:22
 2:26
2:26
2025-10-22 14:10
 3:18
3:18
2025-10-28 10:36
 3:02
3:02
2025-10-25 13:03
 2:37
2:37
2025-10-28 10:22
 2:28
2:28
2025-10-17 12:00
 3:08
3:08
2025-10-22 14:26
 2:29
2:29
2025-10-25 12:48
 3:27
3:27
2025-10-28 11:18
 2:15
2:15
2025-10-22 14:16
 3:18
3:18
2025-10-24 12:09
 4:15
4:15
2025-10-26 12:52
 3:04
3:04
2025-10-24 11:30
 3:13
3:13
2025-10-18 09:47
 4:38
4:38
2025-10-23 11:27
0/0
 1:29:32
1:29:32
2025-09-15 11:39
 1:49:20
1:49:20
2025-10-21 22:50
 1:27:40
1:27:40
2025-08-27 17:17
 2:35:53
2:35:53
2025-08-26 11:45
 1:34:38
1:34:38
2025-08-28 15:32
 1:38:22
1:38:22
2025-10-01 12:16
 1:32:52
1:32:52
2025-08-15 19:31
 1:55:08
1:55:08
2025-10-29 16:30
 1:28:32
1:28:32
2025-10-07 09:27
 2:36:13
2:36:13
2025-10-07 09:27
 1:46:40
1:46:40
2025-10-07 09:27
 1:50:38
1:50:38
2025-10-16 16:08
 2:15:54
2:15:54
2025-10-13 19:02
 1:53:35
1:53:35
2025-09-11 08:20
 2:57:46
2:57:46
2025-08-31 01:03
 2:02:20
2:02:20
2025-10-01 12:06
 1:46:00
1:46:00
2025-08-27 17:17
 1:46:45
1:46:45
2025-10-02 20:45
 1:54:48
1:54:48
2025-10-01 15:17
 2:13:21
2:13:21
2025-09-09 12:49
0/0
 7:00
7:00
2025-06-01 11:15
2021-09-22 23:51
 6:30
6:30
2022-03-31 18:49
 7:09
7:09
2023-07-06 19:20
 7:09
7:09
2025-08-19 17:20
 13:06
13:06
2024-11-28 16:30
 6:30
6:30
2022-03-31 13:09
 1:50:38
1:50:38
2025-10-29 16:37
 11:04
11:04
2023-05-18 16:41
 13:00
13:00
2024-12-02 13:15
 1:20:52
1:20:52
2025-09-19 17:54
2021-09-23 00:15
 10:21
10:21
2025-09-11 10:05
 1:19:50
1:19:50
2024-12-17 16:00
 12:41
12:41
2024-11-28 12:54
2021-09-22 22:45
 13:00
13:00
2024-11-28 16:19
 11:06
11:06
2022-04-01 15:56
2021-09-22 22:29
 7:21
7:21
2025-10-07 09:00
0/0

